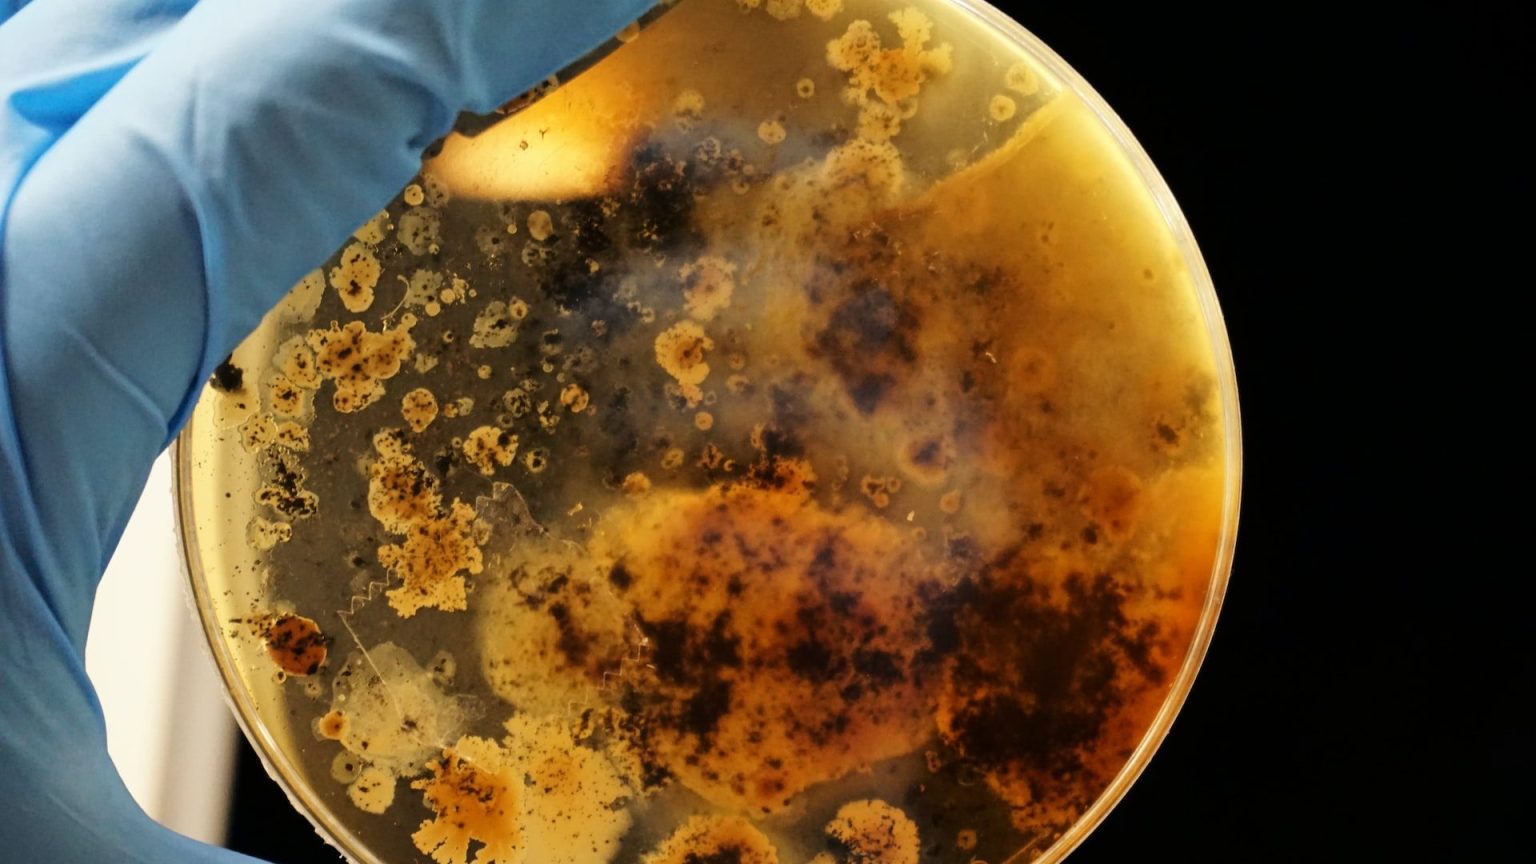

Biohacking
The first 10 minutes of sleep can unlock your creative potential
According to prior research, the first ten minutes of sleep, called N1, can provide a creative boost when it comes to solving problems.
5 biotech trends to watch in 2023
After a monumental year of breakthroughs, scientists, investors, and CEOs share which areas of biotech they are eagerly watching this year.
Engineered bacteria may one day prevent kidney stones
In a small proof-of-concept study, an engineered E. coli was able to reduce levels of a kidney stone-causing chemical.
Harvard and Kraft Heinz are trying to make sugar healthier
Instead of replacing sugar, Wyss scientists had an idea: what if they change sugar to make it healthier?
Armadillo experiment suggests that we can regenerate human livers with leprosy
M. leprae-infected armadillos develop enlarged, healthy livers with gene expression patterns similar to human fetal livers.
Genetically engineered bacteria make living materials for self-repairing walls and cleaning up pollution
With just an incubator and some broth, researchers can grow reusable filters made of bacteria to clean up pollution and more.
Axolotls can regenerate their brains
Axolotls are a model organism researchers use to study a variety of topics in biology because of their regenerative abilities.
Transhumanism: Savior of humanity or false prophecy?
While many of the technologies upon which transhumanists base their dream are real and world-changing, they have major limitations.
How natural “short sleepers” thrive on 4 hours of sleep per night
Natural "short sleepers" thrive on only four to six hours of sleep per night. Could their genetics explain why?
This smart mattress will help you fall asleep fast
UT Austin engineers have developed a smart mattress that manipulates a person’s body temperature to help them fall asleep fast.